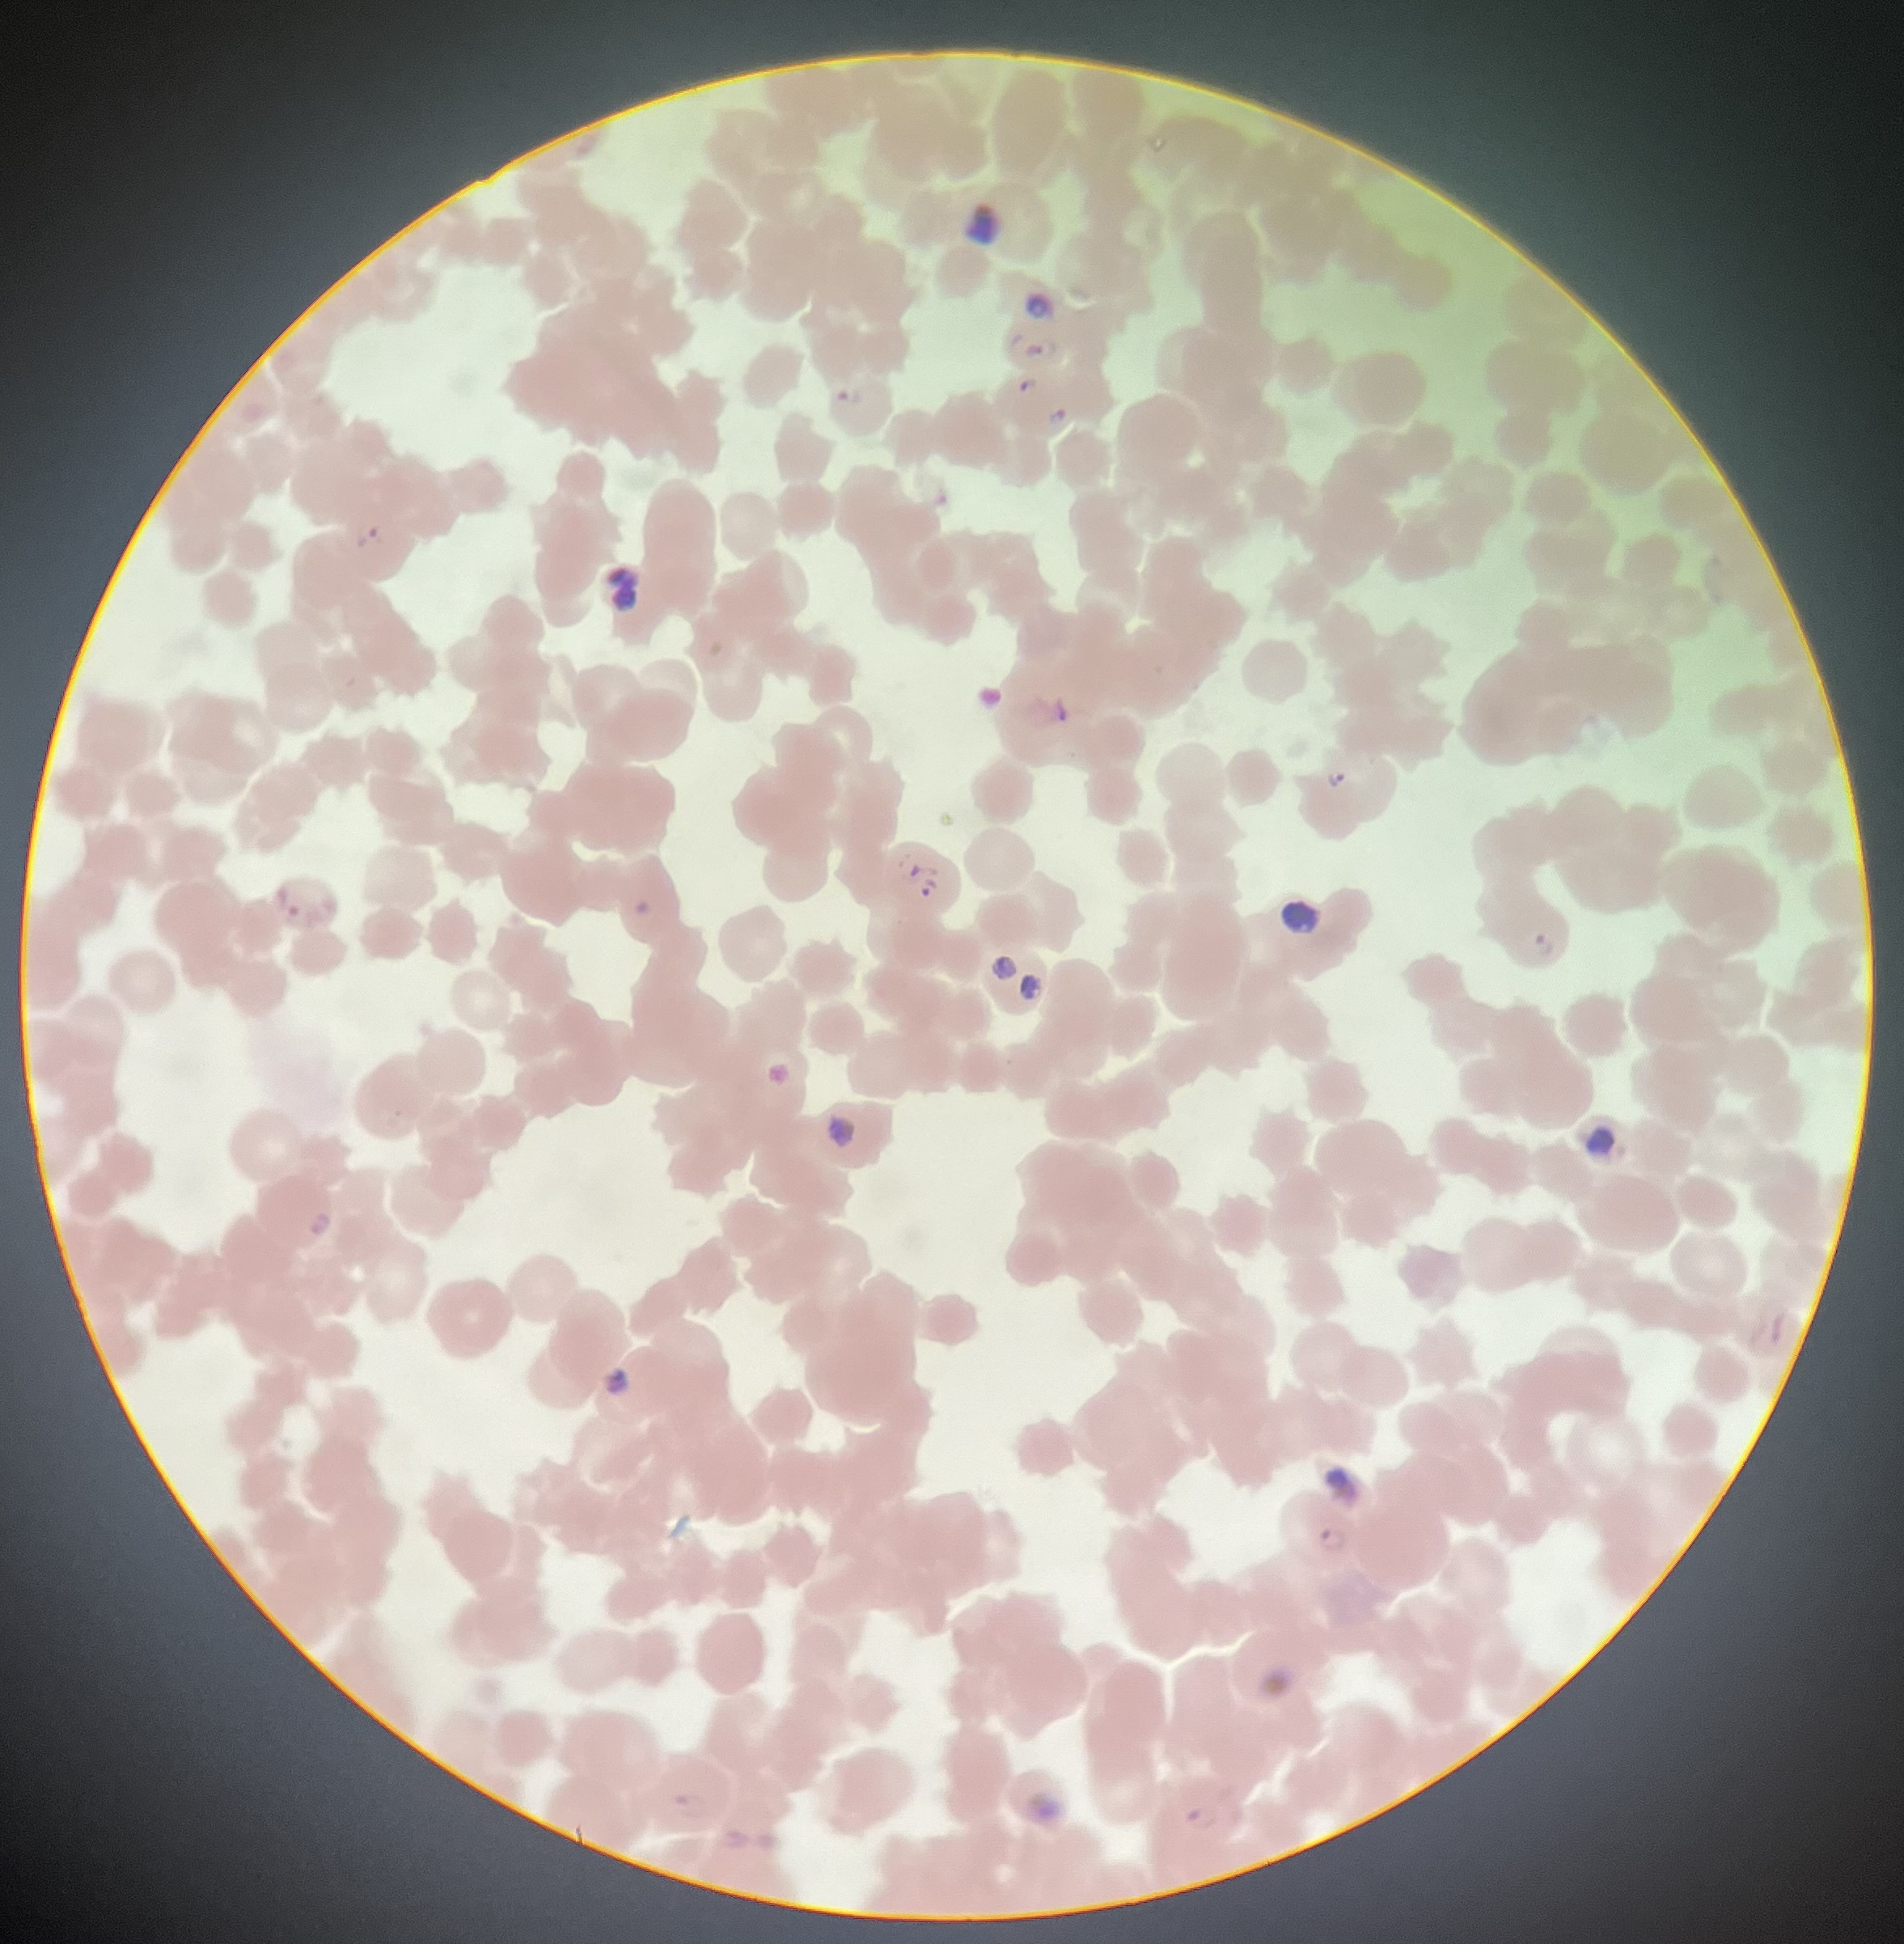
knowt flashcard image
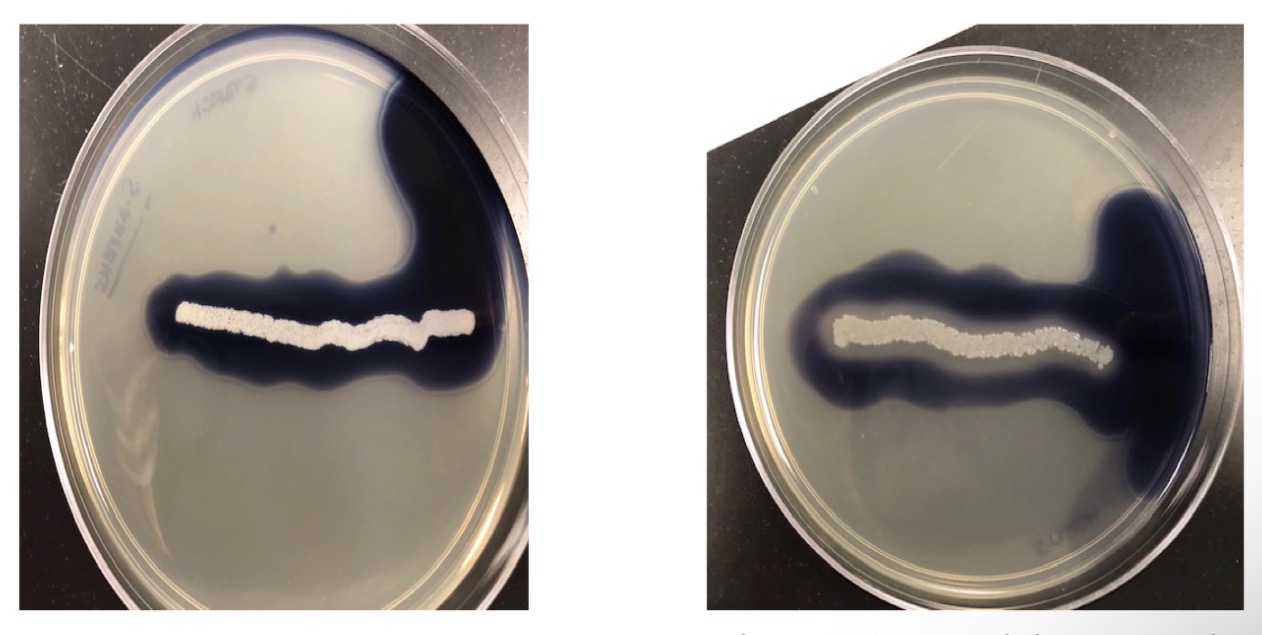
<p><span>Positive: clearing around growth</span></p><p><span>Neg.: no clearing</span></p>

microbio lab final
1/31
There's no tags or description
Looks like no tags are added yet.
Name | Mastery | Learn | Test | Matching | Spaced | Call with Kai |
|---|
No study sessions yet.
32 Terms
Balantidium coli- cyst

Giardia lamblia (intestinalis)-cyst and trophozoite

Trypanosoma gambiense

Trichomonas vaginalis

Plasmodium sp.
Taenia solium (egg)

Schistosoma mansoni (egg)

Enterobius vermicularis (egg)

Enterobius vermicularis (adult)

Dirofilaria immitis (adult)

Diphyllobotrium latum (egg)

Candida albicans

Trichophyton mentagrophytes

S. pyogenes

S. pneumoniae

S. aureus

S. epi

N. gonorrhoea

GC smear

T. pallidum

MAC
Selects for gram neg (growth = gram neg)
Pink/purple CFU = pos. lactose fermentation
MSA
Selects for gram pos. halophiles (salt-tolerant/halotolerant bacteria)
staphylococcus
micrococcus
bacillus
enterococcus
Differential based on ability to ferment mannitol
Yellow = pos. mannitol fermentation
BA
Used for the growth of fastidious microbes (microorganisms difficult to cultivate due to complex or limited nutritional requirements)
Differential through hemolysis
Alpha-hemolysis: partial hemolysis, produces a green-yellow zone of the media around the
bacterial colony.
Beta-hemolysis: complete hemolysis, produces a clearing of the media around the bacterial
colony.
Gamma-hemolysis: no hemolysis, no change to the media around the bacterial colony.
Alpha-hemolysis
partial hemolysis, produces a green-yellow zone of the media around the
bacterial colony
Beta-hemolysis
complete hemolysis, produces a clearing of the media around the bacterial colony
Gamma-hemolysis
no hemolysis, no change to the media around the bacterial colony
Starch hydrolysis
Positive: clearing around growth
Neg.: no clearing
Simmons citrate
Purpose: identify ability to utilize citrate as carbon and energy source

SIM
Purpose: identify motility, indole production, hydrogen sulfide production

Lactose/Mannitol (phenol red) broth
Purpose: identify lactose/mannitol fermentation

MRVP
Purpose: Identify glucose fermentation pathway: mixed acid or butanediol
MR = methyl red
identifies mixed acid pathway
req addition of methyl red
VP = voges-proskauer test
identifies butanediol pathway
req alpha naphthol and KOH
Snyder media
tests susceptibility to dental caries
Yellow/orange after 24 & 48 hrs =pos/high susceptibility
Green after 24 & 48 hrs =neg/low susceptibility